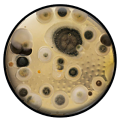
A Cleaner Image

Other Contractors

LL Flooring
Special Offer: Try our Agent Assist shopping experience!
5139 Highway 52 N,
Rochester, 55901-01
507-216-0978
View detail page - LL Flooring

Rochester Electric & Communications
421 15th Ave NE,
Byron, 55920
507-280-6468
We can handle all your electrical needs.
Rochester Electric & Communications offers your top of the line electrical services. We serve Rochester, Red WIng, Winona, Austin-Albert Lea, and Fairbault-Owatonna areas. Our goal is to meet your needs ...
View detail page - Rochester Electric & Communications

John Lindahl
Special Offer: Call Today!
533 3rd Ave NE,
Pine Island, 55963
507-280-8856
View detail page - John Lindahl

Nuehring Concrete Inc
616 1st St N,,
Rockwell, 50469
641-425-5323
View detail page - Nuehring Concrete Inc

AccuPave Inc.
40 Dubelbeiss Ln,
Rochester, 14622
585-342-2420
AccuPave, the premier asphalt company and paving contractor in Rochester, NY, specializes in driveway resurfacing, asphalt patching, parking lot sealcoating, and parking lot striping. Since their beginnings in 1994, the company has been ...
View detail page - AccuPave Inc.

Tile Creations By Valerie
2973 W. Henrietta Road,
Rochester, 14623
585-424-5450
Tile Creations by Valerie in Rochester, NY specializes in all types of tile including ceramic, porcelain, stone, glass and much more. We have an extensive selection of new, fashionable tiles from renowned brands around the world. Our knowledgeable ...
View detail page - Tile Creations By Valerie

Pierce Industries
465 Paul Road,
Rochester, 14624
585-458-0888
We specialize in providing custom manufacturing solutions to our Customers. Our overall goal is to reduce production time and material cost to increase competitiveness in the marketplace.
View detail page - Pierce Industries

Arrow Kitchens & Bath
168 West Main St,
Webster, 14580
585-670-9910
Arrow Kitchens & Bath has been in the kitchen and bath industry since 1965 and is located at 168 West Main Street, Webster, New York. We service all of Rochester, the surrounding suburbs, and surrounding counties. Our showroom is filled with ...
View detail page - Arrow Kitchens & Bath

Coffey Construction Company
69 Great Neck Rd,
Waterford, 06385
860-701-0271
View detail page - Coffey Construction Company

Impact Painting
883 Lake Ave,
Rochester, 14613
585-254-0040
Exterior upgrades can take many forms, but one of the oldest and more personal methods of exterior improvement comes in the form of painting. Impact Painting in Rochester, NY, is ready to put brush to canvas. Family owned and operated, this ...
View detail page - Impact Painting

Lon Lockwood Electric
590 Salt Road,
Webster, 14580
585-766-4702
Lon Lockwood Electric specializes in residential installation, repair, and maintenance of electrical work in Rochester, New York. As a locally owned company, we understand the pride of Rochester, NY residents in our great city and the surrounding ...
View detail page - Lon Lockwood Electric

PumperJack Septic
Special Offer: Pumping Logs, Clearing Clogs
14145 NY-31,
Savannah, 13146
315-926-5597
View detail page - PumperJack Septic
Products and Services

Hibbs Contracting
80 Clark Street,
Canandaigua, 14424
585-337-9042
We believe that using quality products is what's best for the consumer. We recommend products that we would use on our own homes and manufacturers that have proven to stand behind their goods. Our team will provide you with exceptional ...
View detail page - Hibbs Contracting

Dennis Ringer & Son, Inc.
332 North Creek Crossing,
Rochester, 14612
585-225-6067
Dennis Ringer & Son, Inc.located in Rochester, NY serves all of Monroe County with home improvement and repair services. In business since 1973, Dennis Ringer & Son Inc specializes in roofing, siding of all kinds, windows, doors, ...
View detail page - Dennis Ringer & Son, Inc.

Universal Heating and Cooling Company
926 W. Main Street,
Rochester, 14611
585-328-1423
Universal Heating has been providing a wide variety of heating and cooling services for the Rochester New York and surrounding areas since 1956. Our services include cleaning, maintenance, installation and sales for residential and commercial ...
View detail page - Universal Heating and Cooling Company

Roto-Rooter Plumbing & Water Cleanup
1200 Buffalo Rd,
Rochester, 14624
585-235-7990
Need a Plumber in Rochester: Call Roto-Rooter Today for a Plumber in Rochester
Roto-Rooter plumbers in Rochester provide full service plumbing maintenance and repairs and clogged drain cleaning, 24 hours a day. Roto-Rooter's Rochester ...
View detail page - Roto-Rooter Plumbing & Water Cleanup

Arctic Refrigeration of Batavia, Inc.
26 Cedar Street,
Batavia, 14020
585-343-2678
View detail page - Arctic Refrigeration of Batavia, Inc.

Isaac Heating & Air Conditioning
2760 Morgan Drive Suite 2,
Avon, 14414
585-226-3800
At Isaac Heating & Air Conditioning, we're all about improving the quality of your life which, for us, starts with improving the comfort of your home. From installing a new furnace or air conditioning to tune-ups and equipment repairs, ...
View detail page - Isaac Heating & Air Conditioning

MADCO Mechanical Services Inc.
1385 Empire Boulevard Bldg. 1,
Rochester, 14609
585-671-0020
From single installations to complete office maintenance, we offer sales, repairs, maintenance, and service on all kinds of heating, air-conditioning, and radiant-heat systems. Providing 24 hour emergency service.
View detail page - MADCO Mechanical Services Inc.

Isaac Heating & Air Conditioning
50 Holleder Parkway,
Rochester, 14615
585-546-1400
When it comes to heating & cooling your home, you're not just buying an HVAC unit — you're buying a company, a customer service team, the quality & integrity they represent. Whether it's an emergency repair, a replacement, ...
View detail page - Isaac Heating & Air Conditioning

Crossfield Heating & Air Conditioning
44 Donovan Street,
Webster, 14580
585-872-4420
View detail page - Crossfield Heating & Air Conditioning
A Cleaner Image
71 Goodway Drive S. Ste 1-35,
Rochester, 14623
585-377-1960
A Cleaner Image is Rochester’s Premier Residential and Commercial Cleaning & Restoration Expert. Our professional cleaning services include: Carpet Cleaning, Tile & Grout Cleaning & Sealing, Upholstery Cleaning, Water Damage ...
View detail page - A Cleaner Image


Simon Schouten & Son, LLC
22 Ryder Hill Rd,
Rush, 14543
585-272-0812
The business originally was started by Simon Schouten over 50 years ago and was formed into an LLC by his son John in 1997. There are many years of experience in this company. Simon has since passed but his son John continues to run the business. ...
View detail page - Simon Schouten & Son, LLC

Carpet Doctor Rochester
1225 Ridgeway Ave, Rochester, New York,
Rochester, 14615
585-225-7252
Carpet Doctor is a family owned and operated carpet and upholstery cleaning business serving both residential and commercial customers throughout the Greater Rochester, NY Area including Greece, Spencerport, Hilton and Gates. Our fully licensed and ...
View detail page - Carpet Doctor Rochester

Ez Livingremodeling
2539 Skelly Rd,
Caledonia, 14423
555-555-5555
Please update this phone #. I currently have this # and get numerous calls a day to verify my google business.
View detail page - Ez Livingremodeling

Business
23 BUsienss CLosed,
Penfield, 14526
585-000-0000
23 BUsienss CLosed23 BUsienss CLosed23 BUsienss CLosed23 BUsienss CLosed23 BUsienss CLosed23 BUsienss CLosed23 BUsienss CLosed23 BUsienss CLosed23 BUsienss CLosed23 BUsienss CLosed23 BUsienss CLosed23 BUsienss CLosed23 BUsienss CLosed
View detail page - Business

SLT Home Inspections
85 Cedarhurst Drive,
West Henrietta, 14586
585-226-7406
SLT Home Inspections has been conducting thorough, affordable home inspection services throughout Rochester, NY and surrounding areas for nearly two decades. Owned and operated by Steven Tracy, Rochester's Top Rated Home Inspector, he proudly ...
View detail page - SLT Home Inspections

Paul Davis Restoration of Greater Rochester, NY
1075 Buffalo Road,
Rochester, 14624
585-647-9933
Paul Davis Restoration of Greater Rochester is NY's most trusted contractor and restoration service for Water Damage, Fire Damage, Flood Damage, Storm Damage, Contents Restoration, and Mold Remediation. Paul Davis prides itself in helping ...
View detail page - Paul Davis Restoration of Greater Rochester, NY

Ron Ferris & Son Roofing
1680 Atlantic Ave,
Walworth, 14568
585-288-0895
Want an affordable roof repair service? Contact Walworth NY's trusted roofing company - Ron Ferris & Son Roofing. We specialize in roof replacement, roof repair, reroofing and roof tear off service. Request your FREE ESTIMATE TODAY!
View detail page - Ron Ferris & Son Roofing

All to Max
-,
Rochester, 14608
585-520-2260
All to Max offers Home Remodeling, Home Improvements, Deck Builder, General Contractor, Siding Contractor in Rochester, NY. Call (585) 520-2260.
We serve in Rochester, NY, East Rochester, NY; and the surrounding areas.
Deck Builder, Deck ...
View detail page - All to Max

Rochester NY Painters
Special Offer: Schedule for a free Consultation!
305 Inglewood Drive,
Rochester, 14619
585-633-8533
View detail page - Rochester NY Painters

Thomas Landscape & Design, Inc.
775 Ridge Road,
Webster, 14580
585-671-8476
Providing landscaping services, landscape mulch, landscape stone, top soil, plants & shrubs, and a full garden center for fertilizers and keeping your yard looking great!
View detail page - Thomas Landscape & Design, Inc.
Curry Copy Center
Special Offer: Call Today!
116 Campbell Ave SW,
Roanoke, 24011
540-345-2865
View detail page - Curry Copy Center

Davis Heating & Air Conditioning
2081 S Main St,
Rocky Mount, 24151
540-369-3790
If you're looking for heating and cooling services or expertise in Rocky Mount look no further than Davis Heating & Air Conditioning. We've been around since 1947, and our staff offers professional services for heating and cooling, ...
View detail page - Davis Heating & Air Conditioning

W.C. Butler Heating and Air Conditioning
301 Walnut Avenue,
Vinton, 24179
540-344-4300
Since our opening, our team has done everything possible to provide expert customer care and workmanship to residents in and around Roanoke, VA. Our services are what keep people coming back and what has allowed us to last for more than 30 years.
View detail page - W.C. Butler Heating and Air Conditioning

Freeman's Windows-Siding & Sunrooms
35 Mckinley Dr,
Henry, 24102
540-483-7285
We have been doing Home Improvements for over 40 years. Offering free estimates for the following: Sunrooms-Screen-Rooms-Metal & Shingle Roofing-Vinyl Replacement Windows-Vinyl Siding-Decks- Garages-Pole Buildings-Awnings & Insulated Patio ...
View detail page - Freeman's Windows-Siding & Sunrooms

Parts Unlimited
817 3Rd St,
Vinton, 24179
540-343-9899
Receive the most cash for used vehicles and scrap metal at Parts Unlimited. Our company offers a wide selection of new and used parts for late model vehicles. We accept vehicle bodies, appliances, and more. When you bring it to us, we weigh it and ...
View detail page - Parts Unlimited

LL Flooring
Special Offer: Try our Agent Assist shopping experience!
356 Apperson Drive,
Salem, 24153
540-765-4200
View detail page - LL Flooring

Sale Concrete Construction Inc.
Serving Area,
Lynchburg, 24502
434-665-6548
Sale Concrete Construction, Inc. is a concrete contractor serving greater Lynchburg, VA. Concrete company for stamped concrete, driveways, & patios in Lynchburg. Driveways & Driveway Extensions Exposed Aggregate Colored Concrete Sidewalks ...
View detail page - Sale Concrete Construction Inc.

Coulson Builders Inc.
1703 Enterprise Dr,
Lynchburg, 24502
434-258-2832
Coulson Builders is a commercial contractor & home builder serving greater Lynchburg. General contractor, commercial builder, commercial construction for Lynchburg, Virginia.
View detail page - Coulson Builders Inc.

O'Byrne Contracting, Inc
2311 North Lee Highway,
Lexington, 24450
540-817-8245
WORK WITH AN EXPERIENCED GENERAL CONTRACTOR
Historic buildings are beautiful and valuable, but they're often drafty and inconvenient. Get the best of both worlds with our restoration services.
View detail page - O'Byrne Contracting, Inc

Welsh Construction
15 North Randolph Street,
Lexington, 24450
540-464-1008
We are an energetic, certified design and remodeling firm located in Lexington, Virginia and working throughout Rockbridge County. Welsh Construction specializes in additions, kitchens, baths, whole house renovations and historic restorations. Call ...
View detail page - Welsh Construction

The Window Men Inc
5218 Fort Ave,
Lynchburg, 24502
434-237-3353
The Window Men Inc. of Lynchburg, Virginia, offers a great selection of products that restore your home or business' appearance. Our family-run business specializes in sales and installation of vinyl replacement windows, vinyl seamless ...
View detail page - The Window Men Inc

Sunburst Vinyl Supply
1731 Sunburst Road,
Evington, 24550
434-525-5577
Sunburst Vinyl Supply is Lynchburg's best source for replacement windows, new construction windows, premium vinyl siding, shutters, & gutters for Lynchburg, VA.
View detail page - Sunburst Vinyl Supply


Little River Painting
8535 Woodlake Drive,
Henrico, 23294
804-908-3700
Little River Painting is family owned and operated in Richmond, VA specializing in residential construction services including, carpentry, renovations, interior painting, exterior painting and carpet and flooring installations. Servicing the ...
View detail page - Little River Painting

Hetrick Painting
12040 Corianna Ln,
Midlothian, 23113
804-914-4220
Hetrick Painting Inc. is fully licensed and insured expert painting company. Serving the community of Richmond, VA for over two decades, you can rest assured we will treat you and your property with pride and respect. We specialize in Deck ...
View detail page - Hetrick Painting

Lighting Maintenance Inc.
2077 East Whitehill Road,
Prince George, 23875
877-279-7373
Founded in 1991, we are a family-owned electrical and lighting contractor that operates and maintains over 200,000 lights in the mid-Atlantic area. We serve commercial, retail, industrial and government sectors with lighting assessments, LED ...
View detail page - Lighting Maintenance Inc.

All Maintenance and Roofing Inc
14321 Winter Breeze Dr. Suite 19,
Midlothian, 23113
804-536-4998
All Maintenance and Roofing provides roofing, gutters, windows, flooring, remodeling, and power washing services to the Chesterfield, VA, area.
View detail page - All Maintenance and Roofing Inc